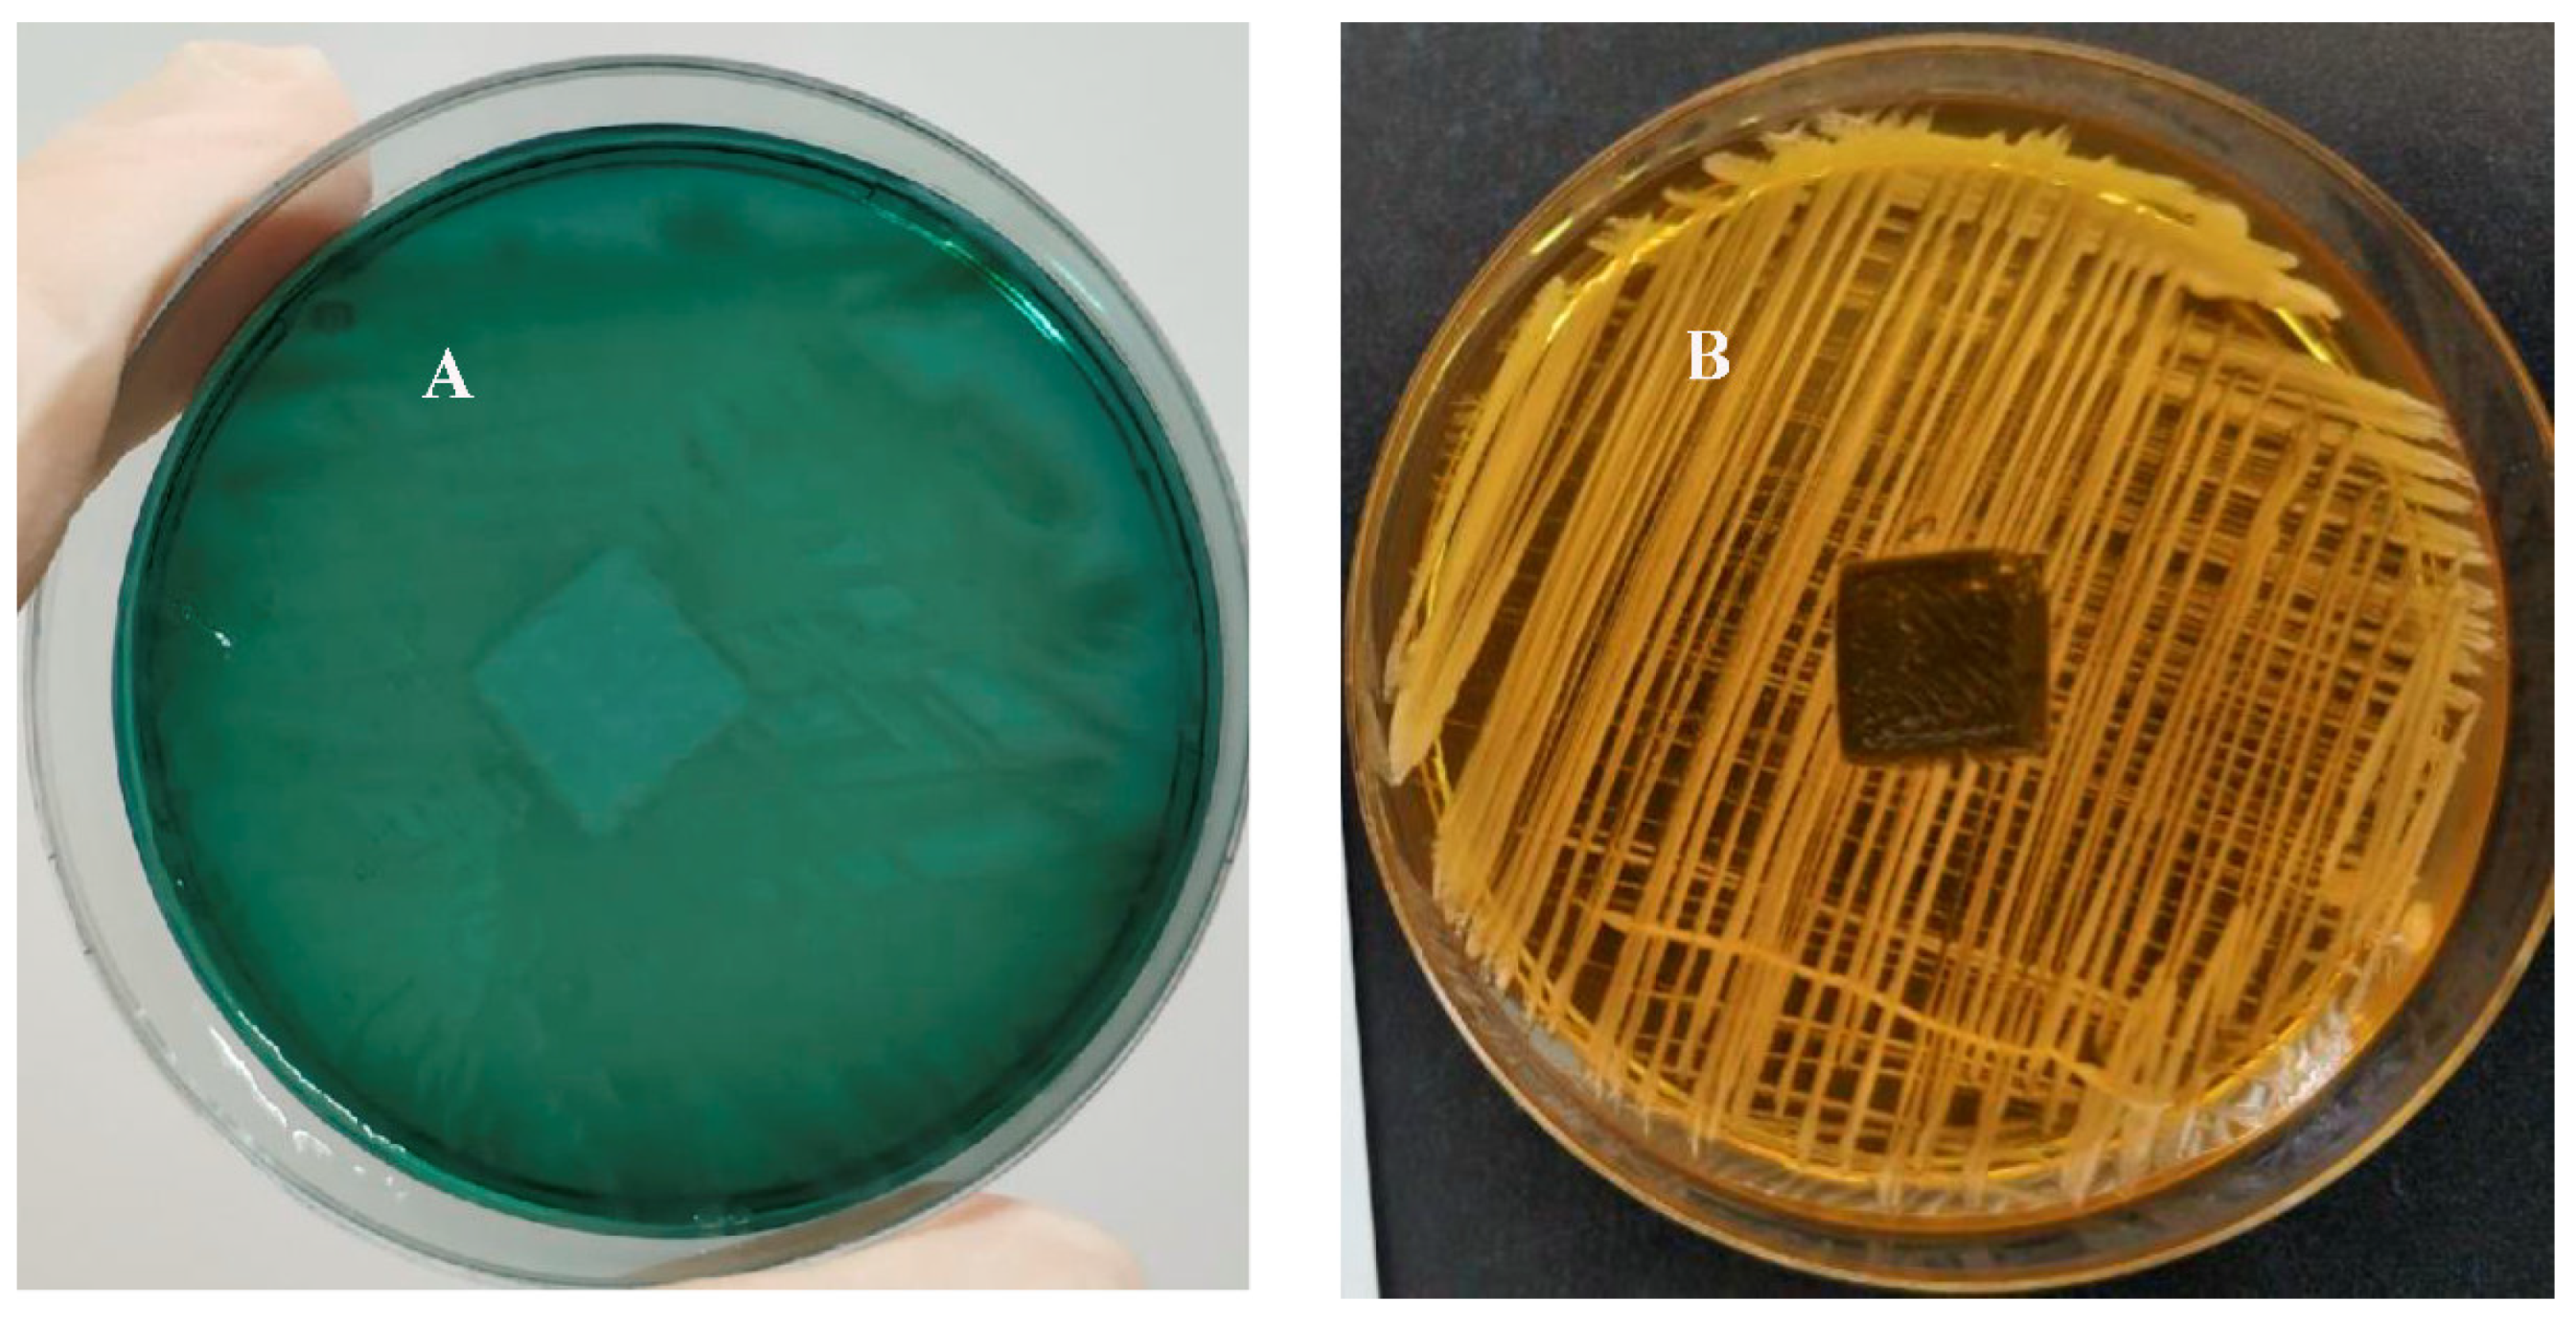
Ijms 23 00086 g005

Sterically Hindered Quaternary Phosphonium Salts (QPSs): Antimicrobial Activity and Hemolytic and Cytotoxic Properties
Abstract
:1. Introduction
2. Results and Discussion
2.1. Antimicrobial and Fungicidal Activity
2.2. Hemolytic and Cytotoxic Activity of QPSs
2.3. Analysis of CV Absorbance Spectra
2.4. Antimicrobial Coating of 3D-Printed Polymeric Surfaces
2.5. Zone-of-Inhibition Test
3. Materials and Methods
3.1. The Synthesis of QPSs
3.2. Antimicrobial Activity
3.3. Hemolytic Activity
3.4. Cytotoxicity Assay
3.5. Crystal Violet Assay
3.6. Evaluation of the Bactericidal Properties of a Plastic Sample
3.7. Zone of Inhibition Test
4. Conclusions
Supplementary Materials
Author Contributions
Funding
Institutional Review Board Statement
Informed Consent Statement
Data Availability Statement
Acknowledgments
Conflicts of Interest
References
- WHO. Available online: https://www.who.int/news/item/29-04-2019-new-report-calls-for-urgent-action-to-avert-antimicrobial-resistance-crisis (accessed on 29 August 2021).
- Davies, J.; Davies, D. Origins and evolution of antibiotic resistance. Microbiol. Mol. Biol. Rev. 2010, 74, 417–433. [Google Scholar] [CrossRef] [PubMed] [Green Version]
- Cassir, N.; Rolain, J.-M.; Brouqui, P. A new strategy to fight antimicrobial resistance: The revival of old antibiotics. Front. Microb. 2014, 5, 551. [Google Scholar] [CrossRef] [PubMed] [Green Version]
- Frieri, M.; Kumar, K.; Boutin, A. Antibiotic resistance. J. Infect. Public Health 2017, 10, 369–378. [Google Scholar] [CrossRef] [PubMed] [Green Version]
- Zrelovs, N.; Kurbatska, V.; Rudevica, Z.; Leonchiks, A.; Fridmanis, D. Sorting out the Superbugs: Potential of Sortase A Inhibitors among Other Antimicrobial Strategies to Tackle the Problem of Antibiotic Resistance. Antibiotics 2021, 10, 164. [Google Scholar] [CrossRef]
- De Oliveira, D.M.P.; Forde, B.M.; Kidd, T.J.; Harris, P.N.A.; Schembri, M.A.; Beatson, S.A.; Paterson, D.L.; Walker, M.J. Antimicrobial Resistance in ESKAPE Pathogens. Clin. Microbiol. Rev. 2020, 33, e00181-19. [Google Scholar] [CrossRef]
- Libertucci, J.; Young, V.B. The role of the microbiota in infectious diseases. Nat. Microbiol. 2019, 4, 35–45. [Google Scholar] [CrossRef]
- Holmes, K.; Bertozzi, S.; Bloom, B.; Jha, P. Major Infectious Diseases, 3rd ed.; World Bank: Washington, DC, USA, 2017; p. 506. [Google Scholar]
- Rohr, J.R.; Barrett, C.B.; Civitello, D.J.; Craft, M.E.; Delius, B.; DeLeo, G.A.; Hudson, P.J.; Jouanard, N.; Nguyen, K.H.; Ostfeld, R.S.; et al. Emerging human infectious diseases and the links to global food production. Nat. Sustain. 2019, 2, 445–456. [Google Scholar] [CrossRef]
- Ndagi, U.; Falaki, A.A.; Abdullahi, M.; Lawal, M.M.; Soliman, M.E. Antibiotic resistance: Bioinformatics-based understanding as a functional strategy for drug design. RSC Adv. 2020, 10, 18451–18468. [Google Scholar] [CrossRef]
- Jones, I.; Joshi, L.T. Biocide Use in the Antimicrobial Era: A Review. Molecules 2021, 26, 2276. [Google Scholar] [CrossRef]
- Pham, T.P.T.; Cho, C.W.; Yun, Y.S. Environmental fate and toxicity of ionic liquids: A review. Water Res. 2010, 44, 352–372. [Google Scholar] [CrossRef]
- Egorova, K.S.; Gordeev, E.G.; Ananikov, V.P. Biological Activity of Ionic Liquids and Their Application in Pharmaceutics and Medicine. Chem. Rev. 2017, 117, 7132–7189. [Google Scholar] [CrossRef]
- Fait, M.E.; Bakas, L.; Garrote, G.L.; Morcelle, S.R.; Saparrat, M.C.N. Cationic surfactants as antifungal agents. Appl. Microbiol. Biotechnol. 2019, 103, 97–112. [Google Scholar] [CrossRef] [PubMed]
- Zhou, C.; Wang, Y. Structure–activity relationship of cationic surfactants as antimicrobial agents. Curr. Opin. Colloid Interface Sci. 2020, 45, 28–43. [Google Scholar] [CrossRef]
- Balgavý, P.; Devínsky, F. Cut-off effects in biological activities of surfactants. Adv. Colloid Interface Sci. 1996, 66, 23–63. [Google Scholar] [CrossRef]
- Lei, Q.; Lai, X.; Zhang, Y.; Li, Z.; Li, R.; Zhang, W.; Ao, N.; Zhang, H. PEGylated Bis-Quaternary Triphenyl-Phosphonium Tosylate Allows for Balanced Antibacterial Activity and Cytotoxicity. ACS Appl. Bio Mater. 2020, 3, 6400–6407. [Google Scholar] [CrossRef]
- Vereshchagin, A.N.; Frolov, N.A.; Egorova, K.S.; Seitkalieva, M.M.; Ananikov, V.P. Quaternary Ammonium Compounds (QACs) and Ionic Liquids (ILs) as Biocides: From Simple Antiseptics to Tunable Antimicrobials. Int. J. Mol. Sci. 2021, 22, 6793. [Google Scholar] [CrossRef]
- Jiao, Y.; Niu, L.-N.; Ma, S.; Li, J.; Tay, F.R.; Chen, J.-H. Quaternary ammonium-based biomedical materials: State-of-the-art, toxicological aspects and antimicrobial resistance. Prog. Polym. Sci. 2017, 71, 53–90. [Google Scholar] [CrossRef]
- Kwasniewska, D.; Chen, Y.-L.; Wieczorek, D. Biological Activity of Quaternary Ammonium Salts and Their Derivatives. Pathogens 2020, 9, 459. [Google Scholar] [CrossRef]
- Alkhalifa, S.; Jennings, M.C.; Granata, D.; Klein, M.; Wuest, W.M.; Minbiole, K.P.C.; Carnevale, V. Analysis of the Destabilization of Bacterial Membranes by Quaternary Ammonium Compounds: A Combined Experimental and Computational Study. ChemBioChem 2020, 21, 1510–1516. [Google Scholar] [CrossRef] [PubMed]
- Costa, S.P.F.; Azevedo, A.M.O.; Pinto, P.C.A.G.; Saraiva, M.L.M.F.S. Environmental Impact of Ionic Liquids: Recent Advances in (Eco)toxicology and (Bio)degradability. ChemSusChem 2017, 10, 2321–2347. [Google Scholar] [CrossRef]
- Devínsky, F.; Pisárcik, M.; Lukác, M. Cationic Amphiphiles. Self-Assembling Systems for Biomedicine and Biopharmacy; Nova Science Publishers: New York, NY, USA, 2017; p. 307. [Google Scholar]
- Telesiński, A.; Pawłowska, B.; Biczak, R.; Śnieg, M.; Wróbel, J.; Dunikowska, D.; Meller, E. Enzymatic Activity and Its Relationship with Organic Matter Characterization and Ecotoxicity to Aliivibrio fischeri of Soil Samples Exposed to Tetrabutylphosphonium Bromide. Sensors 2021, 21, 1565. [Google Scholar] [CrossRef]
- Kimmig, J.; Jerchel, D. Die Wirkung von Invertseifen auf die durch Pilze und Kokken bedingten Hautkrankheiten. Klin. Wochenschr. 1950, 28, 429–431. [Google Scholar] [CrossRef]
- Kanazawa, A.; Ikeda, T.; Endo, T. Synthesis and antimicrobial activity of dimethyl- and trimethyl-substituted phosphonium salts with alkyl chains of various lengths. Antimicrob. Agents Chemother. 1994, 38, 945–952. [Google Scholar] [CrossRef] [PubMed] [Green Version]
- Cieniecka-Rosłonkiewicz, A.; Pernak, J.; Kubis-Feder, J.; Ramani, A.; Robertson, A.J.; Seddon, K.R. Synthesis, anti-microbial activities and anti-electrostatic properties of phosphonium-based ionic liquids. Green Chem. 2005, 7, 855–862. [Google Scholar] [CrossRef]
- Thasneema, K.K.; Thayyil, M.S.; Rosalin, T.; Elyas, K.K.; Dipin, T.; Sahu, P.K.; Kumar, N.S.K.; Saheer, V.C.; Messali, M.; Hadda, T.B. Thermal and spectroscopic investigations on three phosphonium based ionic liquids for industrial and biological applications. J. Mol. Liq. 2020, 307, 112960. [Google Scholar] [CrossRef]
- Martín-Rodríguez, A.J.; Babarro, J.M.F.; Lahoz, F.; Sansón, M.; Martín, V.S.; Norte, M.; Fernández, J.J. From Broad-Spectrum Biocides to Quorum Sensing Disruptors and Mussel Repellents: Antifouling Profile of Alkyl Triphenylphosphonium Salts. PLoS ONE 2015, 10, e0123652. [Google Scholar] [CrossRef] [PubMed] [Green Version]
- Khasiyatullina, N.R.; Mironov, V.F.; Gumerova, S.K.; Voloshina, A.D.; Sapunova, A.S. Versatile approach to naphthoquinone phosphonium salts and evaluation of their biological activity. Mendeleev Commun. 2019, 29, 435–437. [Google Scholar] [CrossRef]
- Minnullin, R.R.; Bakhtiyarova, Y.V.; Morozov, M.V.; Bakhtiyarov, D.I.; Shulaeva, M.P.; Pozdeev, O.K.; Gerasimov, A.V.; Galkina, I.V.; Galkin, V.I. Synthesis, structure and bioactivity of novel carboxylate phosphabetaine derivatives with long alkyl chains. Phosphorus Sulfur Silicon Relat. Elem. 2019, 194, 476–479. [Google Scholar] [CrossRef]
- Lukác, M.; Pisárcik, M.; Garajová, M.; Mrva, M.; Dušeková, A.; Vrták, A.; Horáková, R.; Horváth, B.; Devínsky, F. Synthesis, Surface Activity, and Biological Activities of Phosphonium and Metronidazole Salts. J. Surfactants Deterg. 2020, 23, 1025–1032. [Google Scholar] [CrossRef]
- Pugachev, M.V.; Shtyrlin, N.V.; Sapozhnikov, S.V.; Sysoeva, L.P.; Iksanova, A.G.; Nikitina, E.V.; Musin, R.Z.; Lodochnikova, O.A.; Berdnikov, E.A.; Shtyrlin, Y.G. Bis-phosphonium salts of pyridoxine: The relationship between structure and antibacterial activity. Bioorg. Med. Chem. 2013, 21, 7330–7342. [Google Scholar] [CrossRef]
- Bedar, J.; Caschera, A.; Foucher, D.A. Access to thermally robust and abrasion resistant antimicrobial plastics: Synthesis of UV-curable phosphonium small molecule coatings and extrudable additives. RSC Adv. 2021, 11, 5548–5555. [Google Scholar] [CrossRef]
- Suer, N.C.; Demir, C.; Unubol, N.A.; Yalç, O.; Kocagoz, T.; Eren, T. Antimicrobial activities of phosphonium containing polynorbornenes. RSC Adv. 2016, 6, 86151–86157. [Google Scholar] [CrossRef] [Green Version]
- Li, L.; Zhou, H.; Gai, F.; Chi, X.; Zhao, Y.; Zhang, F.; Zhao, Z. Synthesis of quaternary phosphonium N-chloramine biocides for antimicrobial applications. RSC Adv. 2017, 7, 13244–13249. [Google Scholar] [CrossRef] [Green Version]
- Bisel, P.; Al-Momani, L.; Müller, M. The tert-butyl group in chemistry and biology. Org. Biomol. Chem. 2008, 6, 2655–2665. [Google Scholar] [CrossRef] [PubMed]
- Schmidbauer, H.; Blaschke, G.; Zimmer-Gasser, B.; Schubert, U. Extreme steric hindrance: Synthesis and structure of the tetra(tert-butyl)phosphonium cation—A case of T-symmetry. Chem. Ber. 1980, 113, 1612–1622. [Google Scholar] [CrossRef]
- Stenzel, V.; Jeske, J.; Mont, W.-W.; Jones, P.G. Supramolecular Soft-Soft Interactions of Diiodo(tert-butyl)(isopropyl)phosphonium Cations with µ2- to µ5-Bridging Iodide Anions. Formation of Chains, Helices, and Columnar Structures. Inorg. Chem. 1997, 36, 443–448. [Google Scholar] [CrossRef]
- Ermolaev, V.; Miluykov, V.; Rizvanov, I.; Krivolapov, D.; Zvereva, E.; Katsyuba, S.; Sinyashin, O.; Schmutzler, R. Phosphonium ionic liquids based on bulky phosphines: Synthesis, structure and properties. Dalton Trans. 2010, 39, 5564–5571. [Google Scholar] [CrossRef]
- Arkhipova, D.M.; Ermolaev, V.V.; Miluykov, V.A.; Gubaidullin, A.T.; Islamov, D.R.; Kataeva, O.N.; Ananikov, V.P. Sterically Hindered Phosphonium Salts: Structure, Properties and Palladium Nanoparticle Stabilization. Nanomaterials 2020, 10, 2457. [Google Scholar] [CrossRef]
- Arkhipova, D.M.; Ermolaev, V.V.; Miluykov, V.A.; Valeeva, F.G.; Gaynanova, G.A.; Minyaev, M.E.; Ananikov, V.P. Tri-tert-butyl(n-alkyl)phosphonium Ionic Liquids: Structure, Properties and Application as Hybrid Catalyst Nanomaterials. Sustainability 2021, 13, 9862. [Google Scholar] [CrossRef]
- Fu, Y.; Wang, F.; Sheng, H.; Xu, M.; Liang, Y.; Bian, Y.; Hashsham, S.A.; Jiang, X.; Tiedje, J.M. Enhanced antibacterial activity of magnetic biochar conjugated quaternary phosphonium salt. Carbon 2020, 163, 360–369. [Google Scholar] [CrossRef]
- Popova, L.B.; Nosikova, E.S.; Kotova, E.A.; Tarasova, E.O.; Nazarov, P.A.; Khailova, L.S.; Balezina, O.P.; Antonenko, Y.N. Protonophoric action of triclosan causes calcium efflux from mitochondria, plasma membrane depolarization and bursts of miniature end-plate potentials. Biochim. Biophys. Acta Biomembr. 2018, 1860, 1000–1007. [Google Scholar] [CrossRef]
- Ali, A.; Jamil, M.I.; Jiang, J.; Shoaib, M.; Amin, B.U.; Luo, S.; Zhan, X.; Chen, F.; Zhang, Q. An overview of controlled-biocide-release coating based on polymer resin for marine antifouling applications. J. Polym. Res. 2020, 27, 85. [Google Scholar] [CrossRef]
- Abdolahi, A.; Hamzah, E.; Ibrahim, Z.; Hashim, S. Application of Environmentally-Friendly Coatings Toward Inhibiting the Microbially Influenced Corrosion (MIC) of Steel: A Review. Polym. Rev. 2014, 54, 702–745. [Google Scholar] [CrossRef]
- Kakakhel, M.A.; Wu, F.; Gu, J.D.; Feng, H.; Shah, K.; Wang, W. Controlling biodeterioration of cultural heritage objects with biocides: A review. Int. Biodeterior. Biodegrad. 2019, 143, 104721. [Google Scholar] [CrossRef]
- Singha, P.; Locklin, J.; Handa, H. A review of the recent advances in antimicrobial coatings for urinary catheters. Acta Biomater. 2017, 50, 20–40. [Google Scholar] [CrossRef] [PubMed] [Green Version]
- Dias, A.M.A.; Marceneiro, S.; Braga, M.E.M.; Coelho, J.F.J.; Ferreira, A.G.M.; Simões, P.N.; Veiga, H.I.M.; Tomé, L.C.; Marrucho, I.M.; Esperança, J.M.S.S.; et al. Phosphonium-based ionic liquids as modifiers for biomedical grade poly(vinyl chloride). Acta Biomater. 2012, 8, 1366. [Google Scholar] [CrossRef]
- Bazaka, K.; Jacob, M.V.; Chrzanowski, W.; Ostrikov, K. Anti-bacterial surfaces: Natural agents, mechanisms of action, and plasma surface modification. RSC Adv. 2015, 5, 48739–48759. [Google Scholar] [CrossRef] [Green Version]
- Madigan, M.T.; Martinko, J.M.; Brock, T.D. Brock Biology of Microorganisms; Pearson Education International: Upper Saddle River, NJ, USA, 2006. [Google Scholar]
- Yagci, M.B.; Bolca, S.; Heuts, J.P.A.; Ming, W.; de With, G. Self-stratifying antimicrobial polyurethane coatings. Prog. Org. Coat. 2011, 72, 305–314. [Google Scholar] [CrossRef]
- Voloshina, A.D.; Gumerova, S.K.; Sapunova, A.S.; Kulik, N.V.; Mirgorodskaya, A.B.; Kotenko, A.A.; Prokopyeva, T.M.; Mikhailov, V.A.; Zakharova, L.Y.; Sinyashina, O.G. The structure—Activity correlation in the family of dicationic imidazolium surfactants: Antimicrobial properties and cytotoxic effect. Biochim. Biophys. Acta Gen. Subj. 2020, 1864, 129728. [Google Scholar] [CrossRef] [PubMed]
- Voloshina, A.D.; Sapunova, A.S.; Kulik, N.V.; Belenok, M.G.; Strobykina, I.Y.; Lyubina, A.; Gumerova, S.K.; Kataev, V.E. Antimicrobial and cytotoxic effects of ammonium derivatives of diterpenoids steviol and isosteviol. Bioorg. Med. Chem. 2021, 32, 115974. [Google Scholar] [CrossRef]
- AAT Bioquest, Inc. Available online: https://www.aatbio.com/tools/ic50-calculator (accessed on 29 August 2021).

![]() | ||
|---|---|---|
| R | X = I, Br | X = BF4 |
| CH3 | 1a * | 1b |
| C2H5 | 2a * | 2b |
| n-C3H7 | 3a * | 3b |
| n-C4H9 | 4a | 4b |
| n-C5H11 | 5a | 5b |
| n-C6H13 | 6a | 6b |
| n-C7H15 | 7a | 7b |
| n-C8H17 | 8a | 8b |
| n-C9H19 | 9a | 9b |
| n-C10H21 | 10a | 10b |
| n-C11H23 | 11a | 11b |
| n-C12H25 | 12a | 12b |
| n-C13H27 | 13a | 13b |
| n-C14H29 | 14a | 14b |
| n-C15H31 | 15a | 15b |
| n-C16H33 | 16a | 16b |
| n-C17H35 | 17a | 17b |
| n-C18H37 | 18a | 18b |
| n-C20H41 | 20a | 20b |
| (a) | |||||||||
| Compound | Minimum Inhibitory Concentration (MIC), µg/mL | ||||||||
| Sa | Bc | Ef | MRSA-1 | MRSA-2 | Ec | Pa | Tm | Ca | |
| 10a | 1.9 ± 0.1 | 3.9 ± 0.2 | 7.8 ± 0.6 | 1.9 ± 0.1 | 3.9 ± 0.2 | 31.3 ± 2.7 | - | 125 ± 11 | 31.3 ± 2.6 |
| 10b | 3.9 ± 0.2 | 7.8 ± 0.6 | 15.6 ± 1.3 | 1.9 ± 0.1 | 3.9 ± 0.2 | 62.5 ± 5.4 | - | 125 ± 10 | 31.3 ± 2.4 |
| 11a | 0.9 ± 0.07 | 1.9 ± 0.1 | 7.8 ± 0.5 | 1.9 ± 0.1 | 0.9 ± 0.08 | 31.3 ± 2.6 | - | 31.3 ± 2.5 | 62.5 ± 5.5 |
| 11b | 0.9 ± 0.07 | 1.9 ± 0.1 | 7.8 ± 0.6 | 0.3 ± 0.02 | 0.5 ± 0.04 | 62.5 ± 5.3 | - | 125 ± 9 | 31.3 ± 2.4 |
| 12a | 0.5 ± 0.03 | 1.9 ± 0.01 | 0.9 ± 0.06 | 0.5 ± 0.03 | 0.5 ± 0.03 | 7.8 ± 0.6 | 62.5 ± 5.5 | 15.6 ± 1.2 | 15.6 ± 1.4 |
| 12b | 0.5 ± 0.03 | 1.9 ± 0.01 | 1.9 ± 0.02 | 1.9 ± 0.1 | 0.5 ± 0.04 | 15.6 ± 1.3 | 125 ± 11 | 31.3 ± 2.4 | 15.6 ± 1.3 |
| 13a | 0.2 ± 0.01 | 0.9 ± 0.07 | 3.9 ± 0.3 | 0.5 ± 0.04 | 0.3 ± 0.02 | 3.9 ± 0.02 | 15.6 ± 1.3 | 125 ± 10 | 15.6 ± 1.2 |
| 13b | 0.2 ± 0.01 | 0.5 ± 0.04 | 1.9 ± 0.1 | 0.3 ± 0.02 | 0.3 ± 0.01 | 7.8 ± 0.6 | 31.3 ± 2.3 | 62.5 ± 5.2 | 7.8 ± 0.5 |
| 14a | 1.9 ± 0.2 | 7.8 ± 0.6 | 1.9 ± 0.1 | 0.5 ± 0.03 | 0.5 ± 0.04 | 1.9 ± 0.1 | 15.6 ± 1.1 | 125 ± 11 | 7.8 ± 0.6 |
| 14b | 0.1 ± 0.008 | 0.9 ± 0.07 | 0.9 ± 0.08 | 0.3 ± 0.01 | 0.3 ± 0.02 | 1.9 ± 0.1 | 7.8 ± 0.6 | 15.6 ± 1.3 | 3.9 ± 0.3 |
| 15a | 0.2 ± 0.01 | 0.5 ± 0.03 | 0.5 ± 0.03 | 0.5 ± 0.02 | 0.5 ± 0.04 | 1.9 ± 0.1 | 7.8 ± 0.7 | 62.5 ± 5.3 | 1.9 ± 0.1 |
| 15b | 0.2 ± 0.01 | 0.5 ± 0.03 | 0.5 ± 0.04 | 0.3 ± 0.01 | 0.5 ± 0.03 | 3.9 ± 0.2 | 3.9 ± 0.2 | 62.5 ± 5.5 | 1.9 ± 0.1 |
| 16a | 0.5 ± 0.04 | 1.9 ± 0.1 | 0.5 ± 0.03 | 1.9 ± 0.1 | 0.5 ± 0.03 | 0.9 ± 0.07 | 31.3 ± 2.7 | - | 1.9 ± 0.1 |
| 16b | 0.5 ± 0.03 | 1.9 ± 0.1 | 0.5 ± 0.04 | 1.9 ± 0.1 | 0.5 ± 0.03 | 1.9 ± 0.1 | 3.9 ± 0.02 | 62.5 ± 5.6 | 3.9 ± 0.2 |
| 17a | 0.2 ± 0.01 | 0.9 ± 0.07 | 1.9 ± 0.1 | 0.9 ± 0.06 | 0.9 ± 0.07 | 15.6 ± 1.2 | 7.8 ± 0.5 | 125 ± 10 | 1.9 ± 0.1 |
| 17b | 0.5 ± 0.04 | 1.9 ± 0.1 | 0.5 ± 0.03 | 1.9 ± 0.1 | 1.9 ± 0.1 | 15.6 ± 1.2 | 7.8 ± 0.6 | 125 ± 10 | 1.9 ± 0.1 |
| 18a | 0.9 ± 0.08 | 7.8 ± 0.6 | 0.9 ± 0.07 | 0.9 ± 0.07 | 0.9 ± 0.07 | 15.6 ± 1.3 | 15.6 ± 1.2 | 125 ± 11 | 1.9 ± 0.1 |
| 18b | 1.9 ± 0.1 | 31.3 ± 2.2 | 1.9 ± 0.1 | 7.8 ± 0.6 | 3.9 ± 0.2 | 15.6 ± 1.3 | 15.6 ± 1.3 | 250 ± 19 | 7.8 ± 0.7 |
| 20a | 3.9 ± 0.2 | 15.6 ± 1.3 | 3.9 ± 0.2 | 7.8 ± 0.6 | 1.9 ± 0.1 | 62.5 ± 5.5 | 31.3 ± 2.4 | 31.3 ± 2.3 | 31.3 ± 2.5 |
| 20b | 3.9 ± 0.2 | 62.5 ± 5.5 | 7.8 ± 0.6 | 15.6 ± 1.3 | 7.8 ± 0.6 | 62.5 ± 5.7 | 125 ± 11 | 250 ± 18 | 15.6 ± 1.3 |
| Ciprofloxacin | 0.5 ± 0.03 | 0.5 ± 0.04 | 3.9 ± 0.3 | 125 ± 11 | 0.9 ± 0.07 | 0.5 ± 0.03 | 0.5 ± 0.03 | ||
| Ketoconazole | 3.9 ± 0.2 | 3.9 ± 0.3 | |||||||
| (b) | |||||||||
| Compound | Minimum Bactericidal and Fungicidal Concentration (MBC, MFC), µg/mL | ||||||||
| Sa | Bc | Ef | MRSA-1 | MRSA-2 | Ec | Pa | Tm | Ca | |
| 10a | 1.9 ± 0.1 | 31.3 ± 2.5 | 7.8 ± 0.6 | 15.6 ± 1.2 | 3.9 ± 0.2 | 31.3 ± 2.6 | - | 125 ± 11 | 31.3 ± 2.3 |
| 10b | 3.9 ± 0.2 | 125 ± 9 | 15.6 ± 1.2 | 15.6 ± 1.3 | 7.8 ± 0.6 | 62.5 ± 5.5 | - | 125 ± 10 | 31.3 ± 2.2 |
| 11a | 1.9 ± 0.1 | 125 ± 10 | 7.8 ± 0.6 | 1.9 ± 0.1 | 7.8 ± 0.6 | 31.3 ± 2.3 | - | 31.3 ± 2.5 | 62.5 ± 5.7 |
| 11b | 3.9 ± 0.2 | 125 ± 10 | 15.6 ± 1.2 | 0.5 ± 0.03 | 0.9 ± 0.07 | 62.5 ± 5.4 | - | 125 ± 9 | 31.3 ± 2.1 |
| 12a | 0.5 ± 0.03 | 62.5 ± 5.3 | 1.9 ± 0.1 | 0.5 ± 0.04 | 7.8 ± 0.6 | 7.8 ± 0.7 | 125 ± 11 | 15.6 ± 1.3 | 31.3 ± 2.7 |
| 12b | 0.5 ± 0.03 | 62.5 ± 5.5 | 15.6 ± 1.3 | 0.5 ± 0.04 | 31.3 ± 2.7 | 15.6 ± 1.2 | 125 ± 10 | 62.5 ± 5.2 | 15.6 ± 1.3 |
| 13a | 0.5 ± 0.04 | 7.8 ± 0.6 | 7.8 ± 0.6 | 0.3 ± 0.02 | 0.5 ± 0.03 | 3.9 ± 0.2 | 31.3 ± 2.4 | 125 ± 10 | 31.3 ± 2.2 |
| 13b | 0.2 ± 0.01 | 31.3 ± 2.3 | 3.9 ± 0.3 | 0.5 ± 0.03 | 3.9 ± 0.3 | 7.8 ± 0.6 | 31.3 ± 2.2 | 62.5 ± 5.3 | 7.8 ± 0.6 |
| 14a | 1.9 ± 0.1 | 15.6 ± 1.3 | 3.9 ± 0.2 | 7.8 ± 0.6 | 62.5 ± 5.3 | 1.9 ± 0.1 | 125 ± 11 | 125 ± 10 | 15.6 ± 1.2 |
| 14b | 1.9 ± 0.1 | 15.6 ± 1.2 | 1.9 ± 0.1 | 0.5 ± 0.03 | 0.5 ± 0.03 | 3.9 ± 0.2 | 62.5 ± 5.4 | 15.6 ± 1.3 | 15.6 ± 1.2 |
| 15a | 0.5 ± 0.03 | 15.6 ± 1.3 | 1.9 ± 0.1 | 0.5 ± 0.04 | 0.5 ± 0.03 | 3.9 ± 0.2 | 7.8 ± 0.6 | 62.5 ± 5.7 | 3.9 ± 0.2 |
| 15b | 0.5 ± 0.03 | 15.6 ± 1.3 | 3.9 ± 0.2 | 0.3 ± 0.01 | 0.5 ± 0.04 | 3.9 ± 0.2 | 3.9 ± 0.3 | 62.5 ± 5.2 | 15.6 ± 1.2 |
| 16a | 0.5 ± 0.03 | 31.3 ± 2.2 | 0.5 ± 0.03 | 7.8 ± 0.6 | 7.8 ± 0.7 | 1.9 ± 0.1 | 125 ± 9 | - | 3.9 ± 0.3 |
| 16b | 0.5 ± 0.03 | 31.3 ± 2.4 | 0.5 ± 0.03 | 15.6 ± 1.2 | 3.9 ± 0.2 | 1.9 ± 0.1 | 62.5 ± 5.3 | 62.5 ± 5.5 | 3.9 ± 0.2 |
| 17a | 0.5 ± 0.03 | 15.6 ± 1.2 | 1.9 ± 0.1 | 0.9 ± 0.07 | 0.9 ± 0.06 | 15.6 ± 1.3 | 7.8 ± 0.7 | 125 ± 10 | 3.9 ± 0.2 |
| 17b | 0.5 ± 0.04 | 15.6 ± 1.3 | 3.9 ± 0.2 | 1.9 ± 0.1 | 1.9 ± 0.1 | 7.8 ± 0.6 | 15.6 ± 1.3 | 125 ± 11 | 7.8 ± 0.7 |
| 18a | 0.9 ± 0.07 | 31.3 ± 2.5 | 0.9 ± 0.07 | 15.6 ± 1.2 | 0.9 ± 0.07 | 15.6 ± 1.1 | 62.5 ± 5.6 | 125 ± 9 | 3.9 ± 0.2 |
| 18b | 3.9 ± 0.2 | 125 ± 11 | 3.9 ± 0.2 | 15.6 ± 1.2 | 3.9 ± 0.3 | 62.5 ± 5.4 | 31.3 ± 2.5 | 250 ± 19 | 15.6 ± 1.2 |
| 20a | 3.9 ± 0.2 | 31.3 ± 2.6 | 7.8 ± 0.6 | 31.3 ± 2.7 | 15.6 ± 1.2 | 62.5 ± 5.5 | 125 ± 11 | 31.3 ± 2.5 | 62.5 ± 5.7 |
| 20b | 3.9 ± 0.3 | - | 15.6 ± 1.3 | 15.6 ± 1.2 | 7.8 ± 0.7 | 62.5 ± 5.5 | - | 250 ± 18 | 31.3 ± 2.1 |
| Ciprofloxacin | 0.5 ± 0.03 | 0.5 ± 0.04 | 3.9 ± 0.3 | 250 ± 19 | 0.9 ± 0.06 | 0.5 ± 0.03 | 0.5 ± 0.03 | ||
| Ketoconazole | 3.9 ± 0.2 | 3.9 ± 0.3 | |||||||
| FDM Polymers | Abbreviation |
|---|---|
| acrylonitrile butadiene styrene | ABS |
| polylactic acid | PLA natural |
| polylactic acid modified | PLA+ |
| polyethylene terephthalate glycol | PETG |
| polycarbonate modified | PC+ |
| nylon | Nylon |
| Concentration of 12a, % | CFU/cm2 | |||||
|---|---|---|---|---|---|---|
| Name of Plastic Samples | ||||||
| ABS | PLA Natural | PLA+ | PETG | PC+ | Nylon | |
| 0 a | 1.3 × 104 | 4.0 × 104 | 8.0 × 104 | 5.0 × 104 | 3.6 × 104 | 4.5 × 104 |
| 0.01 | - | - | - | - | - | 2.0 × 102 |
| 0.001 | 2.5 × 103 | 5.0 × 103 | 1.6 × 104 | 1.8 × 103 | 1.2 × 104 | 3.2 × 104 |
Publisher’s Note: MDPI stays neutral with regard to jurisdictional claims in published maps and institutional affiliations. |
© 2021 by the authors. Licensee MDPI, Basel, Switzerland. This article is an open access article distributed under the terms and conditions of the Creative Commons Attribution (CC BY) license (https://creativecommons.org/licenses/by/4.0/).
Share and Cite
Ermolaev, V.V.; Arkhipova, D.M.; Miluykov, V.A.; Lyubina, A.P.; Amerhanova, S.K.; Kulik, N.V.; Voloshina, A.D.; Ananikov, V.P. Sterically Hindered Quaternary Phosphonium Salts (QPSs): Antimicrobial Activity and Hemolytic and Cytotoxic Properties. Int. J. Mol. Sci. 2022, 23, 86. https://doi.org/10.3390/ijms23010086
Ermolaev VV, Arkhipova DM, Miluykov VA, Lyubina AP, Amerhanova SK, Kulik NV, Voloshina AD, Ananikov VP. Sterically Hindered Quaternary Phosphonium Salts (QPSs): Antimicrobial Activity and Hemolytic and Cytotoxic Properties. International Journal of Molecular Sciences. 2022; 23(1):86. https://doi.org/10.3390/ijms23010086
Chicago/Turabian StyleErmolaev, Vadim V., Daria M. Arkhipova, Vasili A. Miluykov, Anna P. Lyubina, Syumbelya K. Amerhanova, Natalia V. Kulik, Alexandra D. Voloshina, and Valentine P. Ananikov. 2022. "Sterically Hindered Quaternary Phosphonium Salts (QPSs): Antimicrobial Activity and Hemolytic and Cytotoxic Properties" International Journal of Molecular Sciences 23, no. 1: 86. https://doi.org/10.3390/ijms23010086
APA StyleErmolaev, V. V., Arkhipova, D. M., Miluykov, V. A., Lyubina, A. P., Amerhanova, S. K., Kulik, N. V., Voloshina, A. D., & Ananikov, V. P. (2022). Sterically Hindered Quaternary Phosphonium Salts (QPSs): Antimicrobial Activity and Hemolytic and Cytotoxic Properties. International Journal of Molecular Sciences, 23(1), 86. https://doi.org/10.3390/ijms23010086


